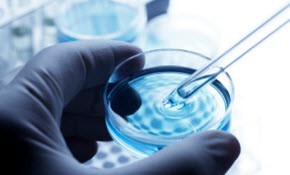
10petriistock_000016354947xsmall 10petriistock_000016354947xsmall

|
|
Through leadership and expertise, Ellyn Pollack has made significant contributions to the field of health and biomedical public relations. Her outreach campaigns in the public and scientific communities enable Americans to make more informed choices that result in improved health outcomes. She has extensive knowledge and expertise in designing health education campaigns on a multitude of diseases, disorders, and conditions. She developed and implemented local, national, and international multi-faceted communications plans to reach people of diverse racial, ethnic, and socioeconomic backgrounds.
Ellyn established strategic outreach plans for a newly established Congressionally mandated office on women’s health research, making a permanent mark in history. As the first Communications Director for the National Institutes of Health (NIH) Office of Research on Women’s Health, she was instrumental in developing a scientific blueprint for women’s health research for the next decade. She was at the forefront when Congress mandated that women and minorities be included in all NIH-sponsored clinical research. She educated the scientific community on the new laws and how to meet these requirements so they would be eligible for future grant money. She also contributed to the advancement of many women in biomedical careers.